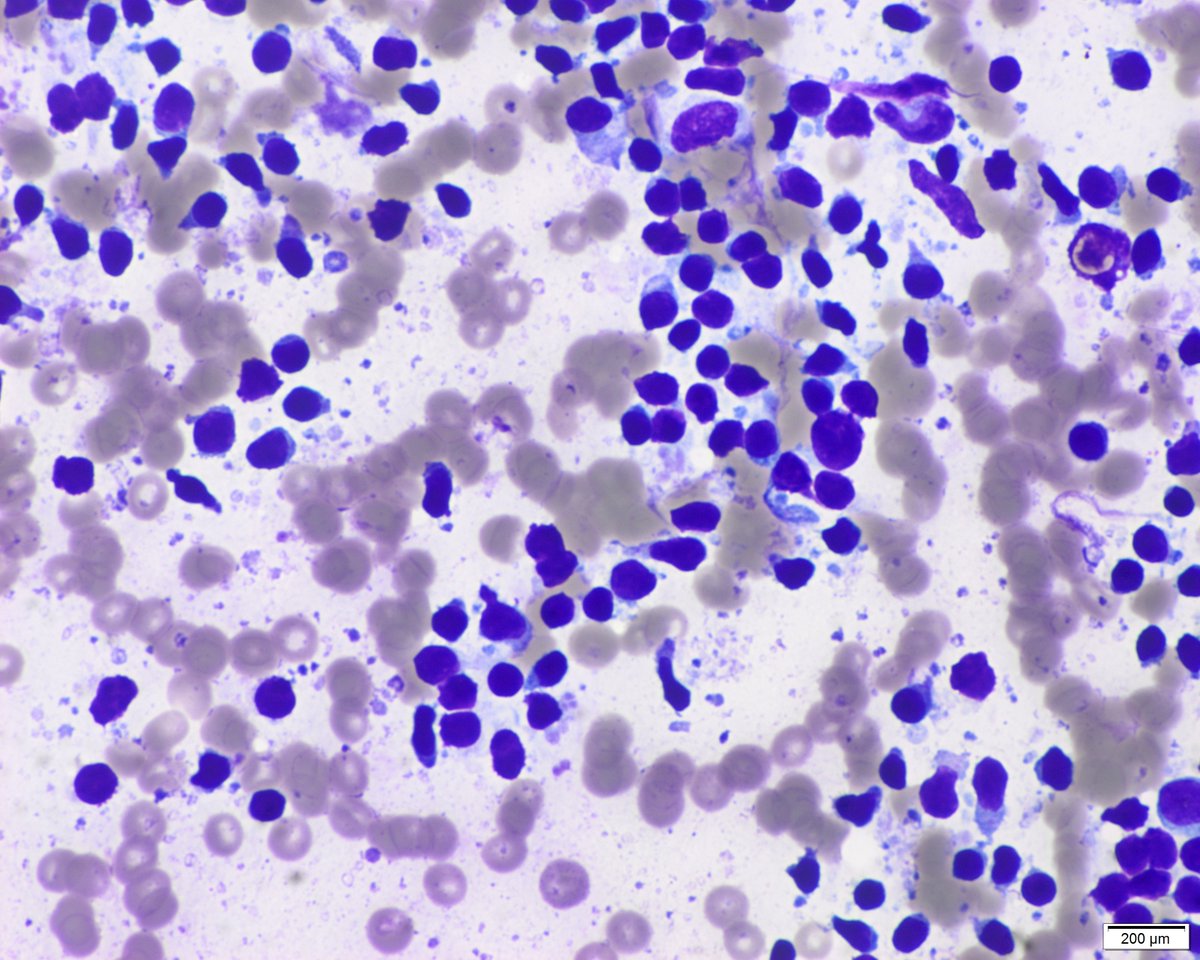
Part 3. Man in his sixties with history of papillary thyroid carcinoma (thyroidectomy). A submental 6 mm node is seen by the endocrinologist. US features are benign (oval with fat in the hilar region). Material for thyroglobulin biochemical analysis is also obtained
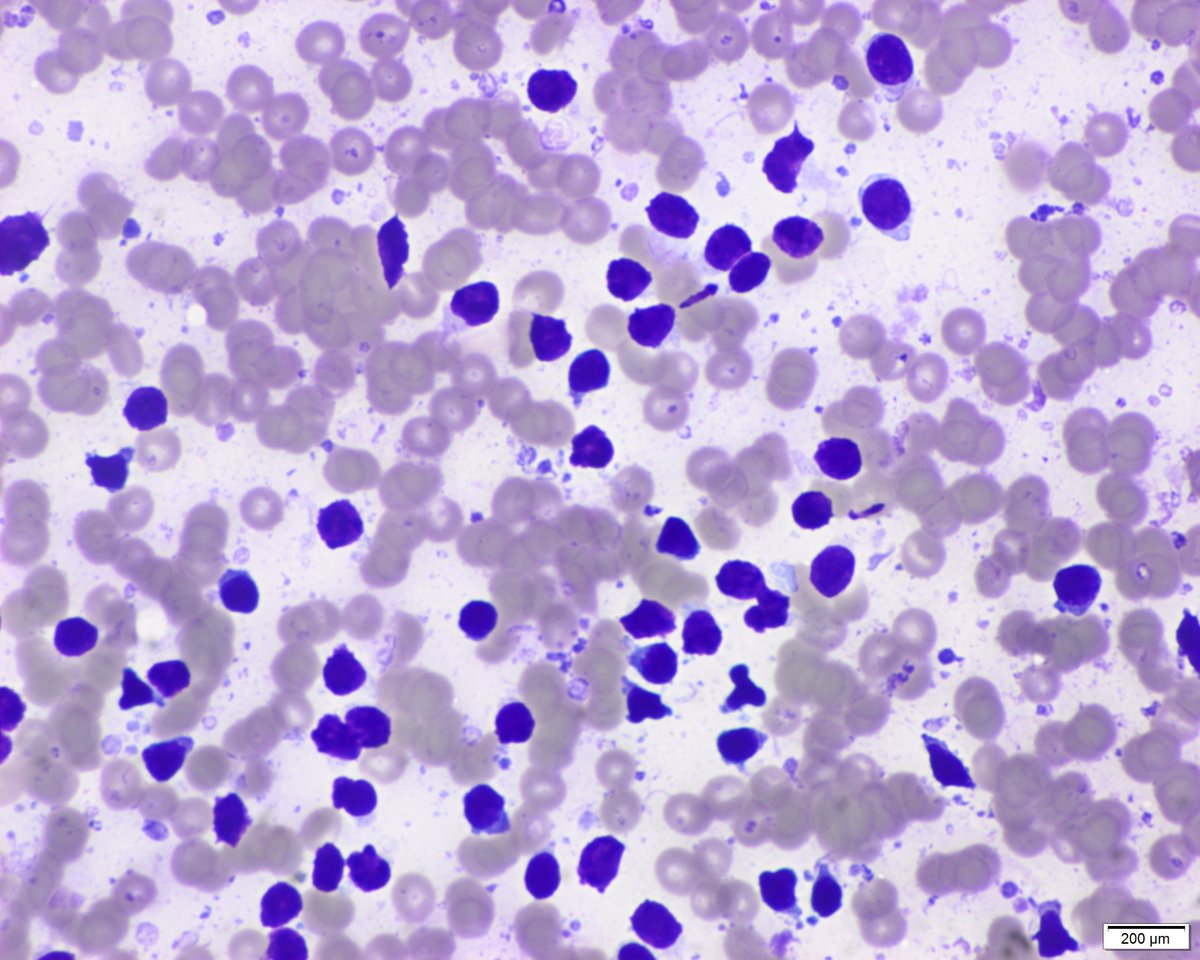
Part 3. Man in his sixties with history of papillary thyroid carcinoma (thyroidectomy). A submental 6 mm node is seen by the endocrinologist. US features are benign (oval with fat in the hilar region). Material for thyroglobulin biochemical analysis is also obtained
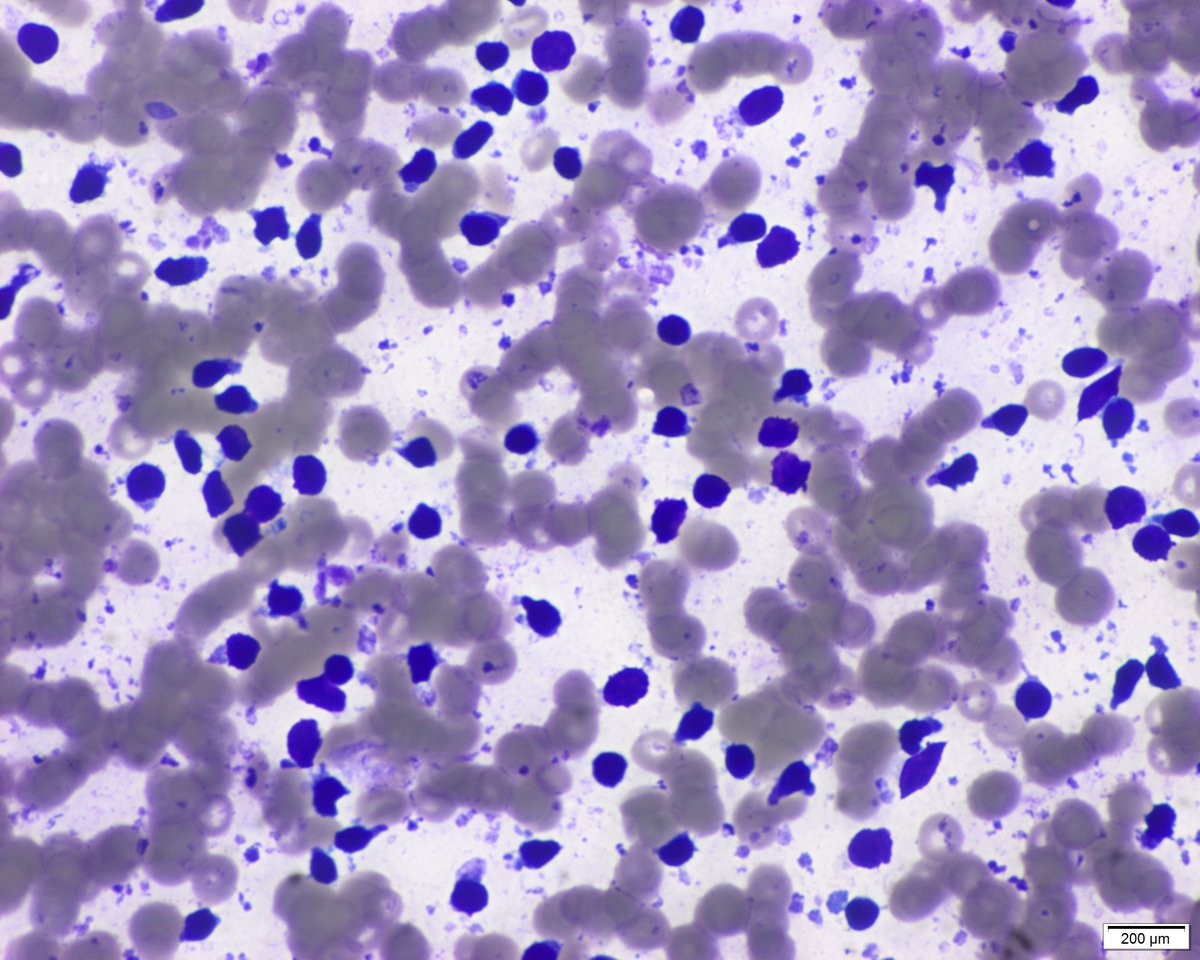
Part 3. Man in his sixties with history of papillary thyroid carcinoma (thyroidectomy). A submental 6 mm node is seen by the endocrinologist. US features are benign (oval with fat in the hilar region). Material for thyroglobulin biochemical analysis is also obtained

Node of the week. @GersonPaull_MD raised an interesting point last week. "A normal node can be very monomorphic without the pleomorphism of reactive nodes with numerous germinal centers": YES. "Defensive" medicine and some clinical contexts led to FNA requests of such nodes
Part 2. Small normal nodes have special problems. First, when small and surrounded by soft tissue (adipose) they move and are dificult to neddle, the pea problem. Second, once the needle is inside and you move it the node accompanies the needle movement and less cells enter it.
Part 3. Man in his sixties with history of papillary thyroid carcinoma (thyroidectomy). A submental 6 mm node is seen by the endocrinologist. US features are benign (oval with fat in the hilar region). Material for thyroglobulin biochemical analysis is also obtained
Part 4. Small lymphocytes (almost as an erythrocyte). Germinal centers and their cells are almost absent. It's a monomorphic image but the small size of the node, cells and clinical context are far away from a lymphoma. But it's very important to be there with the radiologist !!
Part 5. You can even see adipocytes from the hilar region of the node (particularly in inguinal ones) and sebocyte cutaneous contamination should not mislead you. If you see this monomoprhism in a 4 cm node: biopsy. But that is the exception. Rutine is what we have shown. Thanks
One last point, if you see the image that contains the sebocyte group you will realize that it belongs to another case. Lymphoid reactive polymorphism is evident. The "normal" monomorphism is seen in previous images. I just wanted to call your attention to this common finding

 Read on Twitter
Read on Twitter